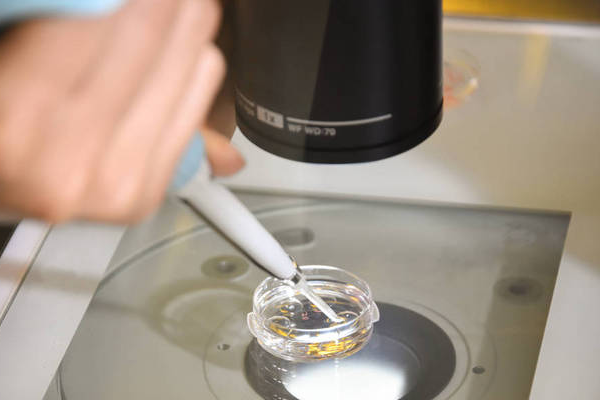
fe7e763cd733883d6b216d96752c6280.png 做试管婴儿成功率有多大

做试管婴儿成功率有多大 可以选择男孩女孩吗
试管婴儿是一种辅助生殖技术,利用外界帮助,将卵子和精子在体外结合,培育成胚胎,再移植到母体内,实现人工受孕的过程。随着科技的不断进步,试管婴儿的成功率逐渐提高,而关于男女选择的问题,也备受备受关注。下面我们就来看看这2个问题吧。
做试管婴儿成功率有多大?
试管婴儿成功率并不是一定的,其成功率受到多种因素的影响,包括年龄、子宫状况、生殖器官疾病等。根据世界卫生组织(WHO)的数据显示,试管婴儿的成功率通常在30%~50%之间。
在35岁以下,成功率大概是40%左右;35岁~37岁的成功率约为30%;37岁~39岁的成功率约为20%,40岁以上女性的成功率则降至10%以下。
不过因为每队夫妇个人情况都有时候不同,所以做试管婴儿的成功率也有所不同,最重要的还是找到适合自己的医院,并努力提高自身身体素质,养成良好的生活习惯,以便确保自身成功率得到提升。
做试管婴儿可以选择男孩女孩吗?
试管婴儿可以通过染色体筛查技术进行性别选择。该技术主要是通过判断染色体中的X和Y两种类型来区分胚胎是男性还是女性。由于是在早期胚胎发育阶段进行,所以并不会对胚胎造成影响。
但在很多国家,包括中国在内,出于伦理道德及社会风险的考虑,选择性别是不被允许的。非医学为目的的筛选胚胎性别是不可以的,只有在有明显的染色体异常及遗传性疾病才可以进行胚胎性别筛查。

总试管婴儿技术的成功率随着年龄的增长而降低,但在专业技术支持下,大多数夫妻仍然可以尝试通过试管婴儿受孕。而关于选择男孩还是女孩的问题,出于伦理道德及社会风险的考虑,在很多地方并不被允许。我们应当尊重科学、尊重生命,通过合法途径来实现生育愿望。
声明:图片来源于网络,如有不当请联系删除
2023-09-22
-
试管婴儿高成功率
点击查看
-
试管婴儿费用/流程
获取详情
-
第三代试管医院
汇总收藏
-
试管婴儿补贴
领取优惠